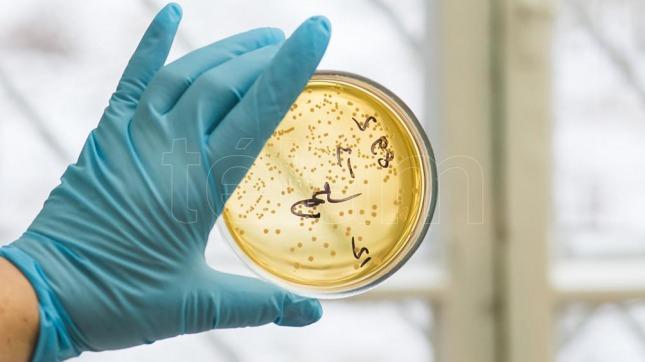

¿Cuál será la primera causa de muerte en 2050?
El uso inapropiado o innecesario de antibióticos en humanos e incluso en la cría de animales es una de las principales causas de la resistencia de las bacterias a medicamentos a los que antes eran vulnerables..
El uso inapropiado o innecesario de antibióticos en humanos e incluso en la cría de animales es una de las principales causas de la resistencia de las bacterias a medicamentos a los que antes eran vulnerables, problemática que se convirtió en una amenaza para la salud pública global, por lo que especialistas afirmaron que la resistencia antimicrobiana (RAM) será la principal causa de muerte en el mundo para 2050.
"El 90 por ciento de nuestros cuerpos está compuesto por bacterias, que residen allí de forma inocua en sus más de 10.000 especies y ayudan a nuestra salud. Sin embargo hay un pequeño grupo de ellas que causa enfermedad", explicó el especialista norteamericano en enfermedades infecciosas Barry Eisenstein durante un Seminario sobre Ciencia y Salud realizado recientemente en Boston, Estados Unidos, del que participó Télam.
El también miembro del Comité de Desarrollo de Medicinas del Instituto Brookings de Washington explicó que "existen dos formas básicas de bacterias: las 'grampositivas' y las 'gramnegativas', que generan diferentes tipos de infecciones y son susceptibles a distintos antibióticos".
"Las bacterias mutan y transfieren sus genes resistentes inclusive entre especies diferentes, por lo que podemos decir que cuanto más se usan los antibióticos más resistentes ellas se vuelven", agregó.
Eisenstein precisó que si bien la RAM es una consecuencia natural del uso de antibióticos, su mal uso hará que se convierta en la principal causa de muerte en el mundo para 2050, ya que enfermedades que estaban erradicadas o eran vulnerables a ciertos fármacos podrían volver a matar y prácticas médicas como la diálisis, la quimioterapia o un trasplante serían prácticamente imposibles debido a las infecciones intrahospitalarias.
"Las infecciones son actualmente la segunda causa de muerte en el mundo y se estima que podrían matar a 10 millones de personas para 2050, más que el cáncer, responsable de 8,2 millones de muertes o la diabetes, que tendrá un número estimado de 1,5 millones de muertes", completó.
Por su parte el médico colombiano Aurelio Otero remarcó la "necesidad urgente" de contar con medicamentos apropiados para tratar las bacterias gramnegativas resistentes: "Tenemos bacterias cada vez más difíciles de combatir y a la vez hay cada vez menos antibióticos para tratarlas", señaló.
"Dentro del gran conglomerado de bacterias gramnegativas existen tres a las que debemos prestar especial atención: las Pseudomonas –responsables principalmente de infecciones en las vías respiratorias, como neumonía-, la Escherichia coli –que genera diarrea- y la Klebsiella –responsable de infecciones intrahospitalarias, principalmente del tracto urinario o de neumonías e infecciones en heridas quirúrgicas-", apuntó.
Otero puntualizó que si bien hay problemas de resistencia en bacterias grampositivas, el problema "fundamental" está dado por las gramnegativas, "responsables del 62 por ciento de las infecciones en las unidades de terapia intensiva de los centros de salud".
"La automedicación o el uso inapropiado de los antibióticos, al que contribuye enormemente la venta libre en las farmacias, o la confusión entre virus y bacterias, que lleva a que muchas veces se usen antibióticos cuando no son necesarios -ya que sólo combaten bacterias-, son dos factores muy importantes que contribuyen a la resistencia a los medicamentos, que son cada vez menos eficaces", resumió.
La RAM genera "un gran impacto en el paciente y en los sistemas de salud, ya que cuando hay bacterias resistentes no sólo aumenta el riesgo de muerte, sino que también se elevan los costos de asistencia hospitalaria", agregó.
"El compromiso es desarrollar antibióticos nuevos y fundamentalmente educar a la población para que los usen apropiadamente, en sus correctas dosis y duración. En eso estamos trabajando", completó.
En ese sentido, el ministro de Salud argentino Jorge Lemus afirmó días atrás durante la Asamblea General de las Naciones Unidas que el país "tiene un fuerte compromiso con el mundo para colaborar en el retraso e impedimento de la emergencia y diseminación de microorganismos resistentes".
"Por eso creamos la Comisión Nacional para el Control de la RAM, encargada de regular la comercialización de antimicrobianos, promover su consumo racional y prudente, detectar a tiempo y controlar las infecciones en hospitales y establecimientos agropecuarios y promover la innovación", detalló.
La Organización Mundial de la Salud (OMS) afirmó que la RAM "compromete la prevención y el tratamiento eficaces de un número cada vez mayor de infecciones causadas por bacterias, parásitos, virus y hongos" y constituye una "amenaza creciente" para la salud pública mundial.
"Por eso se requiere con urgencia la adopción de medidas por parte de todos los sectores gubernamentales y de la sociedad en general", alertó.
Por "resistencia a los antibióticos" se entiende específicamente la resistencia a los antibióticos que desarrollan las bacterias comunes causantes de infecciones, mientras que la RAM es un concepto más amplio y comprende la resistencia a los fármacos utilizados para tratar infecciones causadas por otros microorganismos, como parásitos, virus y hongos.
Por Lucía Toninello para Télam